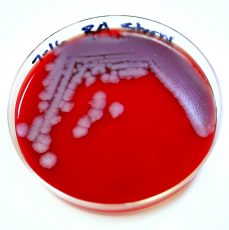

Today on the show: How the 2001 anthrax false flag attacks paved way for Afghanistan and Iraq invasions. Also, the US fears China’s expanded influence after being run out of Afghanistan by the Taliban. And we rebroadcast our interview with Rafia Zakaria/ author, attorney, and human rights activist

